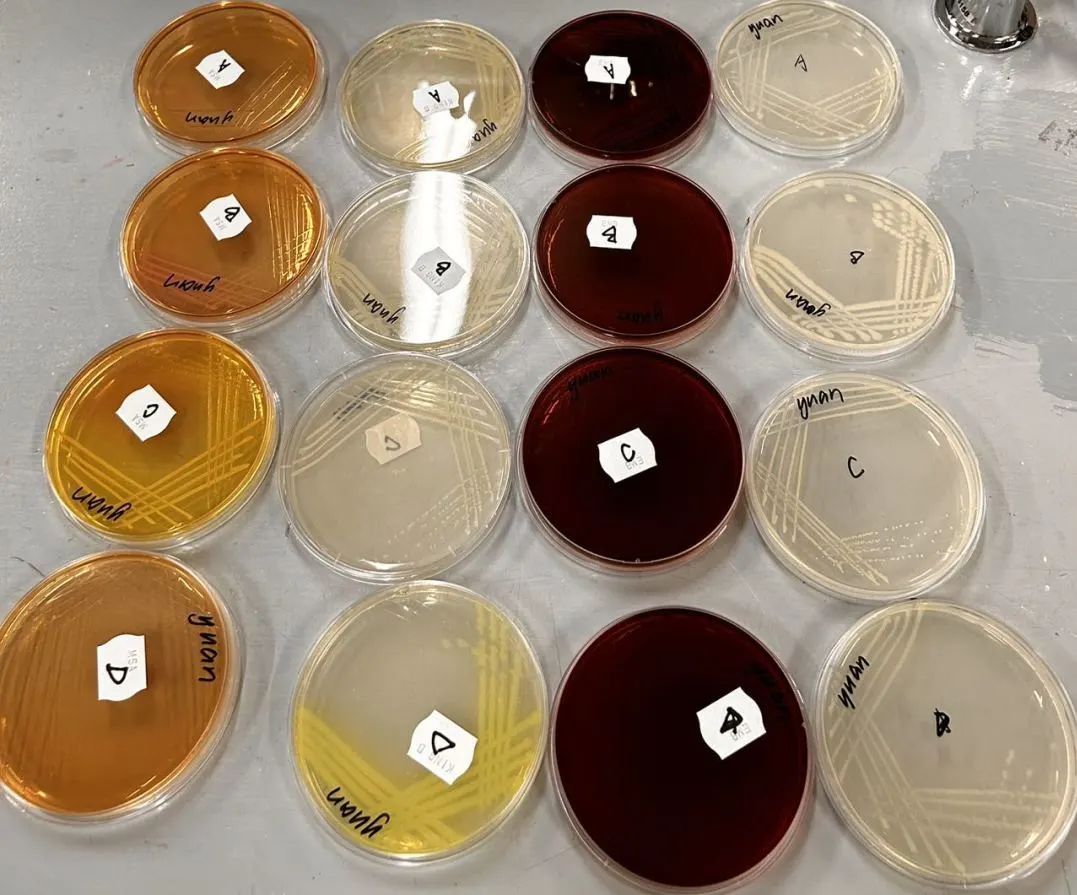

2023年8月5日,304永利集团赴塔斯马尼亚大学短期访学团共10人从重庆出发,奔赴澳大利亚霍巴特,开启了为期两周的暑期访学之旅。

访学团在重庆国际江北机场合影
经过近两天的长途跋涉,访学团于8月6日顺利到达美丽的霍巴特,入住塔大历史悠久、文化氛围浓厚的Jane Franklin Hall员工公寓。

国际员工向访学团介绍公寓设施和员工活动
8月7日,访学活动正式开始。访学团在塔大语言中心Alexandra老师的带领下参观了塔大校园,尤其是电子信息工程、食品质量与安全两个专业上课的主要教学楼,熟悉了住宿周围和市区环境。通过第一天的参访活动,同学们对塔大、霍巴特以及澳大利亚文化有了进一步了解,逐渐适应在塔大的访员工活。


访学团参观塔斯马尼亚大学


Alexandra老师介绍塔大校园和澳洲文化
8月8日至9日,访学团深入塔大课堂,开展了内容丰富、形式多样的专业学习活动。电子信息工程专业和食品质量与安全专业的同学们在各自的课堂上认真听课,完成了小组讨论、实验操作等各项内容,并积极主动与授课教师和塔老员工交流沟通。通过课堂学习,同学们不仅强化了专业知识,还有机会接触到学科的最前沿技术和发展趋势,进一步提高了学习兴趣,开拓了国际视野。




访学团电子信息工程专业员工上专业课

访学团食品质量与安全专业员工上专业课


访学团向专业课教师赠送304永利集团纪念品
8月8日至9日,访学活动还穿插安排了西塔员工与塔大国际员工进行友好的交流互动,提升了国际交流能力与团队合作能力。


访学团与塔大国际员工交流互动
访学团还特别邀请了正在塔大攻读TIA博士项目的304永利集团2016级刘崇岳同学,向同学们分享自己申请博士项目的经历、以及在塔大的学习和生活经验。

西塔2016级刘崇岳同学向访学团分享留学经验
8月9日下午,访学团在塔大体育老师的带领下参观了塔大体育馆,开展了具有当地特色的体育活动,还与塔大师生进行了友好的篮球对抗赛。


访学团在塔大体育馆开展体育活动
食在塔大

参加公寓欢迎晚宴

感受当地中餐


品尝塔州美食
愉快的旅程已经开启,精彩的故事未完待续,敬请期待。



